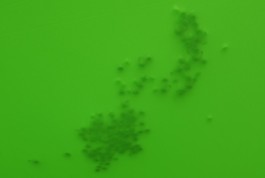

Selection of art-works from the years 2000 - 2012


'#7'
2012
wood, fishing thread, paint (magenta, red)
Re-rotterdam Gallery 10 Rotterdam (NL)
pictures by Ed Jansen
4x4 meter








'saturated'
For this installation I used 12 meters long green stretch fabric and a large amount of jingle bells.
I suspended the fabric at a height of 1.75m throughout the room and distributed the jingle bells over the fabric. By tensioning the fabric, I disturbed the direct view to the second floor. Through the choice to place the fabric low, the visitor who is standing down in the space below moved the fabric with their head or hands up while walking they moved the jingle bells to create noise.
The visitor who is at the top looking onto the fabric could only see the movements and silhouettes
of the other visitor.
pictures by Lotte Stekelenburg
2008
wood, 'greenbox' fabric, metal hooks/wire, jingle bells
Gallery Hommes Rotterdam (NL)
12x4x1.80 meter








'hexagon2007'
is based on the shape of the honeycomb, a structure that consists of hexagonal cells that liaise with each other. I used this structure for an installation that covered all the surfaces of a project space. I installed the hexagons on the floor, each with a distance of 1.5 m between the opposing points- just enough for a person to stand in. I fixed flexible fabric at each flat side of the hexagons, which was stretched 2 meters up to the ceiling. The elongation of the fabric created openings, allowing the visitor to walk through the installation and getting a view into the space.
pictures by Lotte Stekelenburg
2007
wood, fabric, rope
Project space 'de Verschijning' Tilburg (NL)
10x7x2 meter









'untitled (antwerpen)'
A space of 13,50x8m was lined with 36 rows, each line hung 8m deep contained 36 strips of fabric, measuring 0,2x2 meters. The total amount of fabric used was 400m and was arranged in a color scale which zig-zagged throughout the installation. You could view this installation from a distance, where you saw places to enter it and were able to get an overall visual of the work, then, you could step inside the labyrinth of fabric, where it was impossible to know where in the installation you were. After entering you had to attempt to recomprehend the work and make your way through it, with your hands stretched out in front of you.
2006
fabric, nylon thread, metal hooks,needles
Stichting Lokaal 01 Antwerpen (BEL)
13.5x8 meter







'blüte'
More than 10.000 laser-cut paper flowers were glued to a group of oak branches without leaves. These branches created a reachable canopy covering a space of 15x10 meters. You entered a huge industrial hall where everything was made from steal and metal. You were surrounded by a functional and repetitive architecture. In the distance of this hall you saw something white, floating. As you moved closer to it you realised that this white cloud consisted of thousands of paper flowers. The sunlight which came into the space gave you the impression that you were walking under a newly grown flower roof.
2005
oak branches, laser cut paper flowers, glue
'heartbreakhotel' old pipe-factory Stork Hengelo (NL)
15x10 meter




'lichtruis'
Outside a 3x4m house with two windows and no entrance, a switch is activated by the viewer. Inside a blowmachine turns on, expelling a layer of glitter from it's resting place atop a black nylon net spanning the entirety of the house. As the glitter floats down it sparkles in the light. This installation had the character of something precious which should be protected. It was something fragile which without its housing would disappear with the wind, and on the other hand, it was powerful like an ammunition storage space (it's actual original use). An explosion of luminous glitter takes place within the house when the viewer activates the installation.
2005
thin squared metal glitter, black net, two lights, switch
former ammunition storage, van Haeften Park, Apeldoorn (NL)
3x4 meter









'untitled (web)'
In a 10x10m open space, nylon thread was held taught between a 3m circle on the ground and a 6x6m square nine meters above. This funnel shape of vertical nylon thread was then woven with sewing machine yarn in a horizontal color range. An entrance to the funnel was created by omitting a single nylon thread. A structure that plays with the viewers perceptions of colossal forms and fragile material. When light catches the installation from different angles depending on the time of day or the viewers position a subtle but powerful realization is made; using the simplest shape and material a contrast and relationship between massive and delicate things can be explored.
2004
nylon thread, sewing thread, metal hooks
"hal d" extern exhibition space for graduation show Enschede (NL)
9x10x10 meter



'swing'
Two 15 meter long ropes were covered using knitted tubes, hung from the ceiling. To the end of each rope I fixed a wooden gym ring.
The dimension of this space was 14.5 x 9 meters. Visitors could use these two rings.
2002
two gym rings, colored wool, plastic rope
'Hall two' AKI academy for autonomous art & design Enschede (NL)
15 meter
Selection of art-works from the years 2000 - 2012


'#7'
2012
wood, fishing thread, paint (magenta, red)
Re-rotterdam Gallery 10 Rotterdam (NL)
pictures by Ed Jansen
4x4 meter

'saturated'
For this installation I used 12 meters long green stretch fabric and a large amount of jingle bells.
I suspended the fabric at a height of 1.75m throughout the room and distributed the jingle bells over the fabric. By tensioning the fabric, I disturbed the direct view to the second floor. Through the choice to place the fabric low, the visitor who is standing down in the space below moved the fabric with their head or hands up while walking they moved the jingle bells to create noise.
The visitor who is at the top looking onto the fabric could only see the movements and silhouettes
of the other visitor.
2008
wood, 'greenbox' fabric, metal hooks/wire, jingle bells
Gallery Hommes Rotterdam (NL)
12x4x1.80 meter








'hexagon2007'
is based on the shape of the honeycomb, a structure that consists of hexagonal cells that liaise with each other. I used this structure for an installation that covered all the surfaces of a project space. I installed the hexagons on the floor, each with a distance of 1.5 m between the opposing points- just enough for a person to stand in. I fixed flexible fabric at each flat side of the hexagons, which was stretched 2 meters up to the ceiling. The elongation of the fabric created openings, allowing the visitor to walk through the installation and getting a view into the space.
2007
wood, fabric, rope
Project space 'de Verschijning' Tilburg (NL)
10x7x2 meter









'untitled (antwerpen)'
A space of 13,50x8m was lined with 36 rows, each line hung 8m deep contained 36 strips of fabric, measuring 0,2x2 meters. The total amount of fabric used was 400m and was arranged in a color scale which zig-zagged throughout the installation. You could view this installation from a distance, where you saw places to enter it and were able to get an overall visual of the work, then, you could step inside the labyrinth of fabric, where it was impossible to know where in the installation you were. After entering you had to attempt to recomprehend the work and make your way through it, with your hands stretched out in front of you.
2006
fabric, nylon thread, metal hooks,needles
Stichting Lokaal 01 Antwerpen (BEL)
13.5x8 meter







'blüte'
More than 10.000 laser-cut paper flowers were glued to a group of oak branches without leaves. These branches created a reachable canopy covering a space of 15x10 meters. You entered a huge industrial hall where everything was made from steal and metal. You were surrounded by a functional and repetitive architecture. In the distance of this hall you saw something white, floating. As you moved closer to it you realised that this white cloud consisted of thousands of paper flowers. The sunlight which came into the space gave you the impression that you were walking under a newly grown flower roof.
2005
oak branches, laser cut paper flowers, glue
'heartbreakhotel' old pipe-factory Stork Hengelo (NL)
15x10 meter




'lichtruis'
Outside a 3x4m house with two windows and no entrance, a switch is activated by the viewer. Inside a blowmachine turns on, expelling a layer of glitter from it's resting place atop a black nylon net spanning the entirety of the house. As the glitter floats down it sparkles in the light. This installation had the character of something precious which should be protected. It was something fragile which without its housing would disappear with the wind, and on the other hand, it was powerful like an ammunition storage space (it's actual original use). An explosion of luminous glitter takes place within the house when the viewer activates the installation.
2005
thin squared metal glitter, black net, two lights, switch
former ammunition storage, van Haeften Park, Apeldoorn (NL)
3x4 meter









'untitled (web)'
In a 10x10m open space, nylon thread was held taught between a 3m circle on the ground and a 6x6m square nine meters above. This funnel shape of vertical nylon thread was then woven with sewing machine yarn in a horizontal color range. An entrance to the funnel was created by omitting a single nylon thread. A structure that plays with the viewers perceptions of colossal forms and fragile material. When light catches the installation from different angles depending on the time of day or the viewers position a subtle but powerful realization is made; using the simplest shape and material a contrast and relationship between massive and delicate things can be explored.
2004
nylon thread, sewing thread, metal hooks
"hal d" extern exhibition space for graduation show Enschede (NL)
9x10x10 meter



'swing'
Two 15 meter long ropes were covered using knitted tubes, hung from the ceiling. To the end of each rope I fixed a wooden gym ring.
The dimension of this space was 14.5 x 9 meters. Visitors could use these two rings.
2002
two gym rings, colored wool, plastic rope
'Hall two' AKI academy for autonomous art & design Enschede (NL)
15 meter